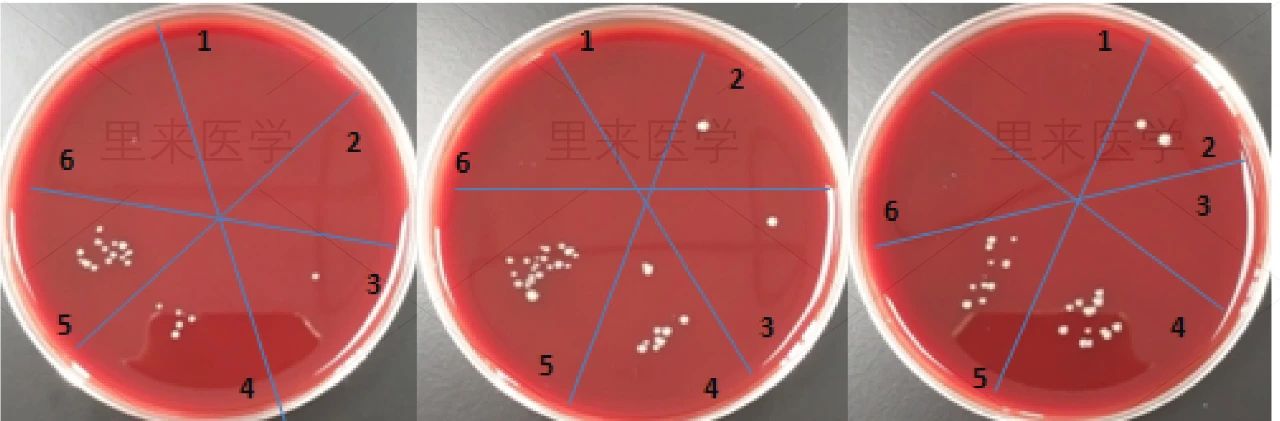

? ? ? ? ?病原微生物是指可以侵犯人體,引起感染甚至傳染病的微生物,或稱病原體。病原體種類非常多,包括病毒、細菌、真菌和其他微生物等。

在科研方面,微生物學檢測已經成為分子生物學創立的支柱之一,基因工程、生物工程、遺傳生物學的創立與發展都離不開微生物學的基礎;在臨床方面,基于病原學證據的抗感染治療也將病原微生物檢測視為金標準,對于改善患者病情與預后,預防和控制環境感染有著重大的意義。
?
?
微生物檢測技術縱覽
?
我們獲得的樣本中,一般都會存在多種細菌,此時需要將樣本進行分離培養,一般分為平板分離培養或血培養。
當平板培養或血培養出現陽性結果時,需要進行微生物鑒定。鑒定一般分為三個層次,其一為菌落形態鑒定,其二為染色鏡檢鑒定,其三為生化鑒定,三者聯合進行結果判斷。而當陽性樣本出現多菌種時,需要重新采樣進行分離培養及純化培養。
?

?
?
?
1 染色鏡檢
?
病原微生物體形微小,大多無色半透明狀,若是肉眼觀察菌落形態還無法判斷的話可將其染色后可借助顯微鏡觀察其大小、形態、排列等,能夠對于形態特殊的病原體進行直觀的檢查,不需要特殊的儀器和設備。

2 生化鑒定
? ? ? 生化方法檢測病原微生物實際上是測定微生物特異性酶。由于各種微生物所具有的酶系統不完全相同,對許多物質的分解能力亦不一致。因此可利用不同底物產生的不同代謝產物來間接檢測該微生物內酶的有無,從而達到檢測特定微生物的目的。

?
?
?
?
?
?
?
?
?
基因層面的檢測技術能夠改善傳統檢測過程中應用外部形態和生理特征進行檢測的現狀,能夠采用特有的基因片段序列對病原微生物的種類進行鑒別,所以基因檢測技術以其自身獨到的優勢被臨床醫學檢驗領域廣泛應用。
?
?
?
1 聚合酶鏈反應(PCR)
?
聚合酶鏈反應(Polymerase Chain Reaction,PCR)是一種在體外是用已知寡核苷酸引物引導未知片段中微量待測基因片段并進行擴增的技術。由于PCR可以對待測基因進行擴增,特別適用于病原體感染早期的診斷。PCR技術在近20年里發展迅速,從基因擴增到基因的克隆和改造以及遺傳分析,可靠性逐步提高。
|
溫江醫學城·分子生物學實驗室 |
QuantStudio3?熒光實時定量分析系統 |
2 基于16S rRNA的檢測技術
?
隨著測序技術發展,DNA大規模測序得以進行,現階段各種常見細菌的16S rRNA基因幾乎全部測序完成,它們相對穩定且有較高的拷貝數(每個細胞幾千個拷貝),其序列中含可變區及高度保守區,因此可設計群、屬、種特異性的探針。
16S rRNA編碼基因的這些特點使之成為較理想的細菌基因分類的靶序列,逐漸成為細菌鑒定、分類的熱門檢測技術。16SrRNA檢測技術利用現有病原菌標準菌株制作DGGE(變性梯度凝膠電泳)標準marker,然后對疑似“病原菌”擴增16SrRNA進行DGGE分析,這樣可以做到快速檢測。
?
|
基因簇(KO)豐度熱圖 |
種水平的精細組成圖 ? |
?
?
?
1 血清學檢測
?
采用血清學檢測能夠對病原微生物進行快速鑒定,血清學檢測技術的基本原理是通過已知的病原體抗原以及抗體對病原體進行檢測,與傳統的細胞分離培養相比,血清學檢驗的操作步驟簡單,其常用的檢測方法之一則為酶聯免疫測試技術等。酶聯免疫測試技術的應用能夠大幅度提高血清學檢測的敏感性和特殊性,不僅能夠對檢測樣本中的抗原進行檢測,還能夠檢測抗體成分。
?
|
酶聯免疫實驗室 |
全波長酶標儀 |
?
2 藥敏實驗
?
傳統藥敏試驗一般分為紙片擴散法、稀釋法、快速藥敏 E-test三種方法,判定標準為最低抑菌濃度MIC值和抑菌圈直徑KB值。
?
制片擴散法:
?
紙片擴散法是將含有定量抗菌藥物的濾紙片貼在已接種了測試菌的瓊脂表面上,紙片中的藥物在瓊脂中擴散,隨著擴散距離的增加,抗菌藥物的濃度呈對數減少,從而在紙片的周圍形成濃度梯度。同時,紙片周圍抑菌濃度范圍內的菌株不能生長,而抑菌范圍外的菌株則可以生長,從而在紙片的周圍形成透明的抑菌圈,不同的抑菌藥物的抑菌圈直徑因受藥物在瓊脂中擴散速度的影響而可能不同,抑菌圈的大小可以反映測試菌對藥物的敏感程度,并與該藥物對測試菌的MIC呈負相關。
?

?
稀釋法:
?
稀釋法藥敏試驗可用于定量檢測待測細菌對待驗證抗菌藥物的抗藥性或敏感性,分為瓊脂稀釋法和肉湯稀釋法。實驗時,抗菌藥物的濃度通常經過倍比稀釋,能抑制待測菌肉眼可見生長的最低藥物濃度成為最小抑菌濃度(MIC),一個特定抗菌藥物的測試濃度范圍應該包含能夠檢測細菌的解釋性折點(敏感、中介和耐藥)的濃度,同時也應該包含質控參考菌株的MIC。
?

?
抑菌實驗結果1-常量肉湯稀釋法
注:圖A直接觀察;圖B加TTC試劑染色觀察
?
?
?
?
?
?
?
?
?
? ? ? 除此之外,免疫學技術、多重PCR技術、核酸雜交技術、基因芯片技術、環介導等溫擴增技術、鏈置換擴增技術、重組酶聚合酶擴增技術、宏基因組測序技術(mNGS)、靶向基因組測序技術(tNGS)、質譜分析技術也被大量應用于微生物檢測中。隨著人類對于病原微生物的檢測手段的不斷升級,希望對于將來生命科學行業有著新的啟示。
里來醫學
基于真實基礎科研
為您提供專業的
一體化微生物與病毒檢測!



長按二維碼關注我吧
?
全國免費熱線?|?400-028-5268
電鏡實驗室技術專線?|?028-87412977
投訴監督專線?| 17711396481














